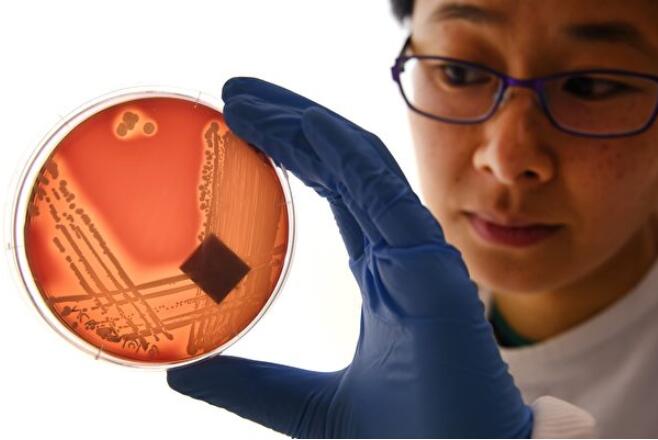

登革热疫情通常出现在热带和亚热带气候,在美国很少见,通常是境外移入。但随着气候变迁,加州洛杉矶史上首次爆发本土...
🔖
感染,
科学家,
环境,
好莱坞,
寨卡病毒,
病毒,
疟疾,
降雨量,
疾病,
免疫力,
孵化,
蚊子,
圣婴现象,

一系列的环境和水文模型表明,由于 21 世纪所发生的气候变化,非洲面临疟疾传播风险的区域可能会比之前预期的进一...

研究人员发现,印尼一只红毛猩猩用草药自制药膏来涂抹伤口。图为2023年8月23日,马来西亚一座国家动物园的苏...

国外科学家在印尼观察到神奇的动物行为,一只苏门答腊猩猩咀嚼完植物后,竟将汁液涂抹在伤口上。
...

蚊子是许多病毒的传播媒介,蚊子传播的疾病包括登革热、日本脑炎和疟疾等,现在科学家又发现另一个病毒...
🔖
感染,
细菌,
细胞,
科学家,
基因,
病毒,
疟疾,
疾病,
基因组,
蚊子,

美国维吉尼亚理工学院生态和演化生物学团队近期发表研究报告指出,多年来全球医疗团队在计算疟疾寄生虫...

美国长春藤盟校塔夫茨大学工程学院通过改变酵母菌上的蛋白传感器,让这种新型的酵母可以更广泛地将“废...
🔖
疫苗,
遗传,
科学家,
基因,
青蒿素,
二氧化碳,
植物,
疟疾,
传感器,
基因组,

夏天炎热酷暑让人难耐,蚊子也让人厌烦,现在日本科学家开发出灭蚊表面活性剂(surfactants...
🔖
科学家,
环境,
蜘蛛,
蚂蚁,
兹卡病毒,
病毒,
疟疾,
纳米,
实验室,
疾病,
全球暖化,
蚊子,
抗药性,

夏天终于来了,带来漫长的白天和充足的阳光,但是也带来一年中最烦人的“蚊子”,这些蚊虫以叮咬而闻名...
一项新研究估计,在2019年全球至少有127万人因耐药性细菌感染失去生命,相当于每天有3,500人因此死亡。卫...
🔖
感染,
抗生素,
细菌,
寄生虫,
微生物,
植物,
病毒,
疟疾,
超级细菌,
金黄色葡萄球菌,
抗药性,